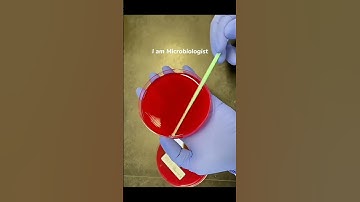
Agar plate streaking

⬇ DOWNLOAD NOW
Kalau muncul iklan pop-up, tutup lalu klik tombol kembali
Download lagu Lab Report in a Nutshell 003 (Rapids in a River) secara gratis hanya untuk keperluan promosi. Dukung artis favorit kamu dengan membeli musik original di iTunes atau platform resmi lainnya.
Agar plate streaking
Agar plate streaking
 3I/ATLAS IS MAKING SCIENTISTS PANIC — SOMETHING IS ALIVE INSIDE THE COMET.
3I/ATLAS IS MAKING SCIENTISTS PANIC — SOMETHING IS ALIVE INSIDE THE COMET.
 WORLDS STRONGEST ACID
WORLDS STRONGEST ACID
 Blue not saving us this time | Jurassic World Rebirth | #jurassicworld #jurassictime
Blue not saving us this time | Jurassic World Rebirth | #jurassicworld #jurassictime
 Nature's Magic: Photosynthesis Experiment with Baking Soda | Dive into the Oxygen Wonderland!
Nature's Magic: Photosynthesis Experiment with Baking Soda | Dive into the Oxygen Wonderland!
 How Eyewash Stations Work 😳
How Eyewash Stations Work 😳
 The Mystery Of Mel’s Hole 😨 (urban legend?)
The Mystery Of Mel’s Hole 😨 (urban legend?)
 Small trench connects river to ocean!
Small trench connects river to ocean!